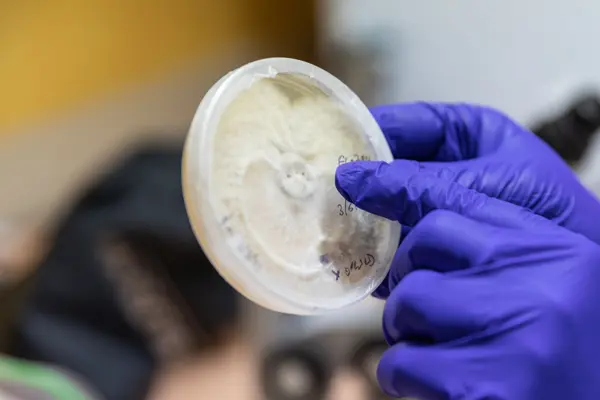

Captivated by Fungi
If you missed the discovery of a new colony of Hypocreopsis amplectens, I’ll “spore” you the details.
After discovering a large population of the scarce and unusual fungus commonly known as Tea-tree Fingers at French Island, Sapphire McMullan-Fisher and the team have a huge task ahead. The scientists based at the National Herbarium of Victoria are working to ensure there is still much room for these fungi in the wild. As Victoria’s only listed threatened fungus, the race is on to create a captive population.

Sapphire McMullan-FisherWe need to create backup populations of this important fungus so that if a site burns or there is another disturbance, then we have a population to use to repopulate that site in the future if needed. We want to be like a zoo with insurance populations.
Growing Tea Tree Fingers in a controlled environment is particularly tricky. It is a mycoparasite, which means it is a fungus that lives on top of another fungus. In growing a captive population, the host fungus must first be developed as a captive population itself. The job involves working on both fungi genomics and seeing how they relate to each other.
“Mycoparasites are interesting in the chemicals they create. For a fungus to live on another fungus, they produce weird chemistry. People may have heard of cordyceps, or ‘zombie fungi’, that forms a parasitic interaction with parasites ants, moths, and beetles; well, this is in the same group. As for conservation and this species ecological importance, we aren’t sure what it does. It may be important in the host fungus’s population control,” McMullan-Fisher says as she examines petri dishes filled with agar and fungi, “I’ve placed over one thousand bits of Tea-tree Fingers tissue onto agar. Still, we haven’t had that eureka moment yet”. Securing their genetics in a culture collection one of the goals.
Tea-tree Fingers was a relatively late discovery, with conservation research around the species coming even later. In Victoria, Tea Tree Fingers was first found in the early 1990s, and at that stage, fungi were thought to be reasonably wide-ranging and more broadly distributed than plants. Three populations were found in the 1990s, while a further was discovered in Greens’ Bush, Mornington Peninsula in the 2000s. A colony located in the Yarra Valley in 2017 was discovered growing on some Kunzea, which was different from the Leptospermum it was discovered growing on at other sites.

Attempts are made to grow host fungi specimens in Petri dishes.
“In 2017, even though it had been FFG listed (Flora and Fauna Guarantee Act), nobody had looked for it for over a decade. When the Yarra Valley population was found, the question was asked whether the other populations had been revisited since they were discovered. Funding was granted, and fortunately, at three of the sites, they still were growing. The Greens’ Bush population on the Mornington Peninsula has been revisited every other year since, and we can not find it. We think that particular population is extinct”.
“The question is raised “who is responsible for monitoring our rare and endangered species?” and it's often enthusiastic people who do that. If it is nobody’s responsibility, it’s easy for a species to go extinct and nobody notices”. McMullan-Fisher reflects upon the initiative taken by citizen science and researchers in ensuring Tea-tree Fingers survival.
The discoveries and wonder of science are both rewarding and satisfying. With a lifetime dedicated to researching plants and fungi, McMullan-Fisher encourages future generations to take up the challenge. “Science is fascinating. If you are concerned about the state of the planet and conservation, there are so many ways people can help. Our brains love problem-solving. If you get a little bit of knowledge, you can be part of the solution. As a kid, I always had the problem of being bored. In science, now, I never have that problem”.
